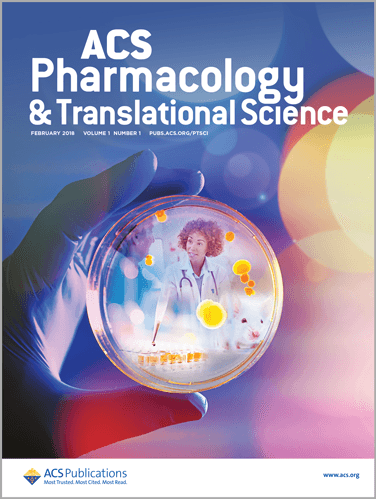

ACS Pharmacology & Translational Science publishes high quality, innovative, and impactful research across the broad spectrum of biological sciences, covering basic and molecular sciences through to translational preclinical studies. Learn more about the journal and how to submit your own research.

ACS Publications and Editor-in-Chief, Professor Patrick M.Sexton, Ph.D., launched ACS Pharmacology & Translational Science earlier this year to provide the community of scientists working across the broad spectrum of pharmacology, biochemistry, and experimental medicine with a place to publish their high-quality, innovative, multidisciplinary research.
“The specific launching of ACS Pharmacology & Translational Science recognizes a gap in publishing opportunities for authors bringing together interdisciplinary sciences and integrating molecular and biological studies to improve the translational relevance of their research,” says Professor Sexton. “We’ve already begun publishing some excellent work that highlights the broad translational scope of the journal and have strong manuscripts in peer review. We encourage you to join in by submitting your team’s research.”
Why Publish in ACS Pharmacology & Translational Science?
It can be hard to evaluate a new journal’s value and quality before it’s had time to establish a reputation, but launched on the long-respected reputation of the ACS Publications portfolio of peer-reviewed journals. That portfolio now contains more than 55 journals, including:
- Journal of the American Chemical Society (JACS) (established: 1879; 2017 Impact Factor: 14.357)
- ACS Central Science (established: 2015; 2017 Impact Factor: 11.228)
- ACS Nano (established: 2007; 2017 Impact Factor: 13.709)
- ACS Infectious Diseases(established: 2015; 2017 Impact Factor: 4.325
- ACS Chemical Neuroscience(established: 2010; 2017 Impact Factor: 4.211)
“ACS has an outstanding reputation as a scientific publisher with a strong commitment to integrity. Chemistry is at the foundation of new medicines, and chemistry and chemical biology have been at the forefront in creating new tools that have revolutionized translational research. As such, ACS Publications is the right partner at the right time to fulfill our mission of creating a new, high-profile, destination for pharmacological and related translational science research,” says Professor Sexton.
When you publish your research with ACS Pharmacology & Translational Science, you get:
- Active researchers as editors. Professor Sexton not only serves as ACS Pharmacology & Translational Science’s Editor-in-Chief but he’s also Professor of Pharmacology and National Health and Medical Research Council (NHMRC) Principal Research Fellow at the Monash Institute of Pharmaceutical Sciences, Monash University. The rest of the journal’s editorial team are also active, practicing researchers.
- High-quality, rapid peer review. ACS Pharmacology & Translational Science follows the thorough peer-review process ACS Publications has honed over the course of more than a century of scientific publishing. Its editors are committed to ensuring rapid, robust review.
- Rapid processing. Accepted articles are available online almost immediately upon acceptance, and the final formatted versions are usually online within two weeks. The journal’s current record is four working days!
- A connection to the global scientific community. ACS may be the American Chemical Society, but it has members, editors, authors, and readers across the globe. The first two peer-reviewed articles published in ACS Pharmacology & Translational Science came from research teams located in six different countries on three continents. And its editors hail from Australia, China, and the U.S.
“Our editorial team provides rapid decisions on whether articles are in scope and sent for review, and works with our reviewers to ensure timely responses to authors,” says Professor Sexton.
Submit Your Research to ACS Pharmacology & Translational Science
If you’re doing innovative research across the broad spectrum of biological sciences, Professor Sexton and the rest of the ACS Pharmacology & Translational Science editorial team invites you to submit your next manuscript to the journal.
“We invite you to submit your research and join our community of authors,” says Professor Sexton. “We’re especially keen to receive studies that fully integrate basic pharmacological and/or biochemical findings into physiological processes that have translational potential in a broad range of biomedical disciplines,” says Dr. Sexton.
The ACS Pharmacology & Translational Science scope includes:
- A broad spectrum of biological sciences —from basic and molecular sciences to translational preclinical studies
- Clinical studies that address novel mechanisms of action
- Methodological papers that provide innovation and advance translation
If you have a question about whether your research fits in the journal’s scope, please send a pre-submission inquiry to eic@ptsci.acs.org.
How to Read ACS Pharmacology & Translational Science
Institutional subscribers to ACS All Publications, All Access, and token packages have access to all of ACS Pharmacology & Translational Science. We encourage librarians at subscribing institutions to add ACS Pharmacology & Translational Science to their link resolvers using ISSN 2575-9108 and https://pubs.acs.org/journal/aptsfn. You can also email your ACS Publications sales representative with any subscription questions related to this new journal at acspusbssales@acs.org.